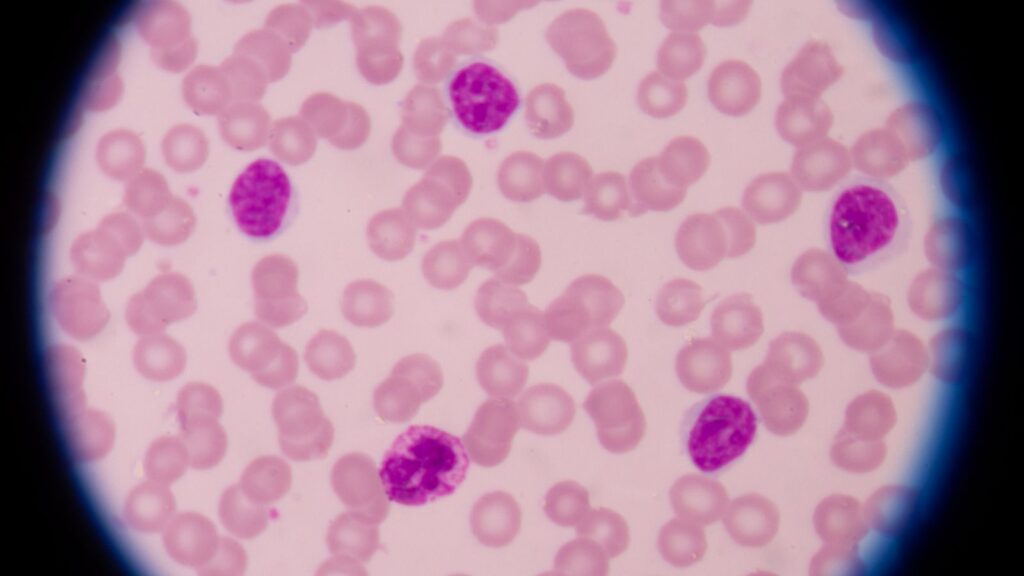

Receiving a diagnosis of chronic lymphocytic leukemia (CLL) can feel overwhelming, especially when trying to understand the range of available treatment options. Advances in medical research and the development of evidence-based guidelines have made it easier for patients and caregivers to navigate these choices. One of the most trusted resources for treatment recommendations is the National Comprehensive Cancer Network (NCCN), which provides regularly updated guidelines to help clinicians deliver optimal care.
This article explains CLL treatment options based on NCCN guidance, helping you understand when treatment is needed, what therapies are available, and how decisions are typically made.
What Is Chronic Lymphocytic Leukemia (CLL)?
Chronic lymphocytic leukemia is a type of cancer that affects the blood and bone marrow. It develops when the body produces abnormal lymphocytes — a kind of white blood cell — that accumulate over time and interfere with normal immune function.
CLL usually progresses slowly compared to other leukemias, and many people live with the condition for years before requiring treatment. Because of this variability, care plans are highly individualized.
When Does CLL Require Treatment?
Not everyone diagnosed with CLL needs immediate therapy. According to NCCN recommendations, treatment typically begins only when the disease shows clear signs of progression or starts causing symptoms.
Common Indicators for Starting Treatment:
- Significant enlargement of lymph nodes, liver, or spleen
- Rapid increase in lymphocyte count
- Falling red blood cell or platelet levels
- Persistent fatigue
- Fever, night sweats, or unexplained weight loss
If these factors are absent, doctors often recommend active surveillance, sometimes called “watch and wait.” This approach avoids unnecessary side effects while ensuring the disease is closely monitored.
Factors That Influence Treatment Decisions
Before selecting a therapy, healthcare providers evaluate several patient-specific and disease-related factors.
Key Considerations Include:
- Genetic mutations and chromosomal abnormalities (such as del(17p) or TP53 mutations)
- Age and overall health
- Presence of other medical conditions
- Previous treatments and response
- Rate of disease progression
Advanced diagnostic testing plays a major role in identifying which therapies may be most effective.
Overview of NCCN-Recommended CLL Treatment Options
Modern CLL treatment has shifted toward targeted therapies that focus on specific biological pathways rather than traditional chemotherapy alone.
For a deeper overview of available cll treatment approaches, educational resources can help patients better understand how these therapies work and what to expect during care.
Below is a general breakdown of the main categories referenced in NCCN guidance.
Targeted Therapy
Targeted drugs are designed to block signals that cancer cells rely on for survival. These treatments have significantly improved outcomes for many people with CLL.
Common Types:
- BTK (Bruton tyrosine kinase) inhibitors – interfere with pathways that help leukemia cells grow
- BCL-2 inhibitors – promote cancer cell death
- PI3K inhibitors – block enzymes involved in cell proliferation
Targeted therapies are often preferred because they can be effective even in higher-risk disease groups.
Immunotherapy
Immunotherapy helps the body’s immune system recognize and attack cancer cells.
Examples Include:
- Monoclonal antibodies that bind to proteins on leukemia cells
- Combination regimens pairing antibodies with targeted drugs
These therapies may be used alone or alongside other treatments depending on the patient’s condition.
Chemoimmunotherapy
Although targeted treatments are increasingly common, chemoimmunotherapy still has a role in certain cases — particularly for younger, fit patients with favorable genetic markers.
This approach combines chemotherapy drugs with immunotherapy to enhance treatment effectiveness.
However, NCCN guidelines increasingly prioritize targeted options due to improved safety profiles and durable responses.
Treatment for Relapsed or Refractory CLL
CLL can sometimes return after treatment or stop responding to a therapy. When this happens, doctors reassess the disease using updated diagnostic tests.
Options may include:
- Switching to a different targeted therapy
- Trying combination regimens
- Enrolling in clinical trials
- Considering cellular therapies in select situations
The availability of multiple drug classes has made sequential treatment strategies more feasible than in the past.
The Role of Clinical Trials
NCCN encourages participation in clinical trials whenever appropriate. These studies provide access to emerging therapies and help researchers refine future treatment standards.
Patients interested in cutting-edge options may want to discuss trial eligibility with their healthcare team.
Managing Side Effects and Quality of Life
Treatment decisions are not based solely on effectiveness — quality of life is equally important.
Common side effects vary depending on therapy but may include:
- Fatigue
- Increased infection risk
- Gastrointestinal symptoms
- Blood count changes
Proactive symptom management, regular monitoring, and open communication with healthcare providers can significantly improve the treatment experience.
Shared Decision-Making in CLL Care
Modern cancer care emphasizes collaboration between patients and healthcare teams. Understanding the risks and benefits of each therapy allows individuals to make informed choices aligned with their preferences and lifestyle.
Questions patients often ask include:
- What is the goal of this treatment?
- How long will therapy last?
- What side effects should I expect?
- How will this impact daily life?
Having these conversations early helps set realistic expectations.
Looking Ahead: The Future of CLL Treatment
Research continues to reshape the CLL landscape. Scientists are studying newer targeted agents, combination therapies, and time-limited treatment strategies designed to maintain long-term remission while minimizing toxicity.
As guidelines evolve, staying informed can help patients better navigate their journey.
Final Thoughts
Understanding CLL treatment options is an important step toward feeling more confident after diagnosis. NCCN guidelines provide a structured, research-driven framework that helps ensure patients receive care aligned with the latest scientific evidence.
Because every case of CLL is unique, treatment decisions should always be made in consultation with qualified healthcare professionals who can tailor recommendations to individual needs.

